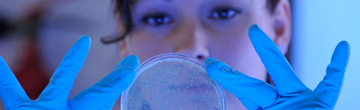

Caroline-von-Humboldt-Preis
Der Caroline-von-Humboldt-Preis wird j?hrlich an eine exzellente Nachwuchswissenschaftlerin für herausragende Forschung verliehen und ist einer der h?chstdotierten Forschungspreise seiner Art in Deutschland.
Preistr?gerin 2023

Kristina Jonutyt?
Dr.in Kristina Jonutyt? arbeitet als Lecturer an der Universit?t Vilnius sowie an der Vytautas-Magnus-Universit?t Kaunas. Jonutyt?s Dissertation über sozialwirtschaftliche Aspekte des st?dtischen Buddhismus wurde mehrfach ausgezeichnet. Ihr HU-Projekt, das sie als Preistr?gerin bei Manja Stephan-Emmrich, Professorin am Institut für Asien- und Afrikawissenschaften, realisieren wird, tr?gt den Titel ?Buryat belonging“ und besch?ftigt sich mit der burjatische Minderheit in Russland und ihre Rolle im aktuellen Ukrainekrieg.?
Preistr?gerin 2022

Corinna Coupette
Corinna Coupette, Mitarbeiterin am Max-Planck-Institut für Informatik in Saarbrücken, überzeugte die Auswahlkommission durch ihre beeindruckende Interdisziplinarit?t. Besonders stachen ihre doppelte Spezialisierung in den Feldern der Rechtswissenschaft und Informatik hervor, eine seltene und herausfordernde Kombination, sowie beachtete Publikationen in beiden F?chern. Diese bilden die Grundlage ihrer wegweisenden bahnbrechenden Forschung im Bereich Juristische Netzwerkforschung, welche einen gro?en methodologischen Fortschritt eines datengetriebenen Ansatzes formuliert. Unterstützt durch den Caroline von Humboldt- Preis wird Corinna Coupette im 2023 ?Scientist in Residence“ an der Juristischen Fakult?t der Humboldt Universit?t zu Berlin.?
Preistr?gerin 2021

Johanna Mugler
Johanna Mugler überzeugte die Auswahlkommission als exzellente Nachwuchswissenschaftlerin durch ihre faszinierende interdisziplin?re Forschung, die sich auf innovative Weise mit Fragen des Rechtspluralismus, der ?berschneidung von Regulierungssystemen und dem Wettbewerb und der Verhandlung über die Legitimit?t von Normen besch?ftigt. Johanna Mugler lehrt und forscht seit September 2012 am Institut für Sozialanthropologie der Universit?t Bern. Unterstützt durch den Caroline von Humboldt- Preis wird Johanna Mugler 2022 ?Scientist in Residence“ an der Juristischen Fakult?t der Humboldt Universit?t zu Berlin.?
Preistr?gerin 2018

Magdalena Gronau
Magdalena Gronau ist Post-Doc Fellow am Seminar für Neuere Deutsche Literaturwissenschaft an der Universit?t Erfurt. Sie überzeugte die Auswahlkommission mit ihrer beeindruckenden wissenschaftlichen Vita und ihrer kreativen transdisziplin?ren Forschung an der Schnittstelle von Natur- und Geisteswissenschaften. Als ?scientist in residence“ wird sie am Institut für deutsche Literatur der HU zum Thema ?‘Verwaschene‘ Physik und ?wackelige Bilder‘. Zur Unsch?rfe der Quantentheorie“ forschen.?
?
Preistr?gerin 2017

Natascha Mehler
Die historische Arch?ologin Natascha Mehler erh?lt den mit 15.000 Euro dotierten Caroline von Humboldt-Preis für ihre kreative interdisziplin?re Forschung, die Ans?tze und Methoden der Arch?ologie, Geschichtswissenschaft, Kunstgeschichte sowie Sozial- und Kulturanthropologie miteinander verknüpft. Am 23. Februar 2018 wurde PD Dr. Natascha Mehler der Caroline von Humboldt-Preis verliehen.?
Preistr?gerin 2016

Margarete Pratschke
Die Kunsthistorikerin erh?lt den mit 15.000 Euro dotierten Caroline von Humboldt-Preis für ihre innovative und herausragende Dissertation sowie ihre Arbeit zu Interdependenzen von Kunstgeschichte und experimenteller Psychologie. Am 6. Dezember 2016 wurde Dr. des. Margarete Pratschke der Caroline von Humboldt-Preis verliehen.?
Preistr?gerin 2014

Annette Brose
Die Psychologin wurde am 15. Dezember 2014 mit dem Caroline-von-Humboldt-Preis ausgezeichnet. Ihr Forschungsprojekt ?Executive control over neutral and emotional material: ist structure and relationship to stress and well-being“ verspricht wichtige Erkenntnisse in einem neuen Forschungsfeld. Es wird für das Institut für Psychologie der Humboldt-Universit?t zu Berlin, wo sie als ?scientist in residence“ angesiedelt sein wird, ausgesprochen gewinnbringend sein.?
?
Preistr?gerin 2013

Noa Shenkar
Die Biologin der Tel Aviv University wird für ihre exzellente Forschungsarbeit zum Thema "Ascidians (Chordata, Ascidiacea) as bio-indicators of the marine environment" ausgezeichnet.
Noa Shenkar hat den Caroline-von-Humboldt-Preis am 26. November 2013 erhalten.
?
Preistr?gerinnen 2012
Am 6. November 2012 haben Claudia Brunner und Cornelia Ebert den Caroline-von-Humboldt-Preis erhalten.

Claudia Brunner
Dr. Claudia Brunner ist derzeit als Universit?tsassistentin und Studienprogrammleiterin am Zentrum für Friedensforschung und Friedensp?dagogik der Alpen-Adria Universit?t Klagenfurt t?tig. Ihr theoretisch anspruchsvolles Projekt ?Epistemische Gewalt. Theoretisierung eines Begriffs“ wurde von der Jury durchweg als ?faszinierend, innovativ und wissenschaftspolitisch au?erordentlich relevant“ beurteilt.
?

Cornelia Ebert
Dr. Cornelia Ebert ist wissenschaftliche Mitarbeiterin am Institut für Linguistik an der Universit?t Stuttgart. Mit ihrem Projekt ?Sprachbegleitende Gesten in der formalen Semantik und Pragmatik“ untersucht sie das Zusammenspiel von Gestik und Sprache. Die Jury begeisterte Frau Ebert durch ihre breite Publikationst?tigkeit und das vielversprechende Forschungsvorhaben.
?
Preistr?gerin 2011

Costanza Toninelli
Die Physikerin arbeitet als Senior Researcher in Florenz. Zuvor war sie als Postdoktorandin an der Eidgen?ssischen Technischen 金贝棋牌 Zürich in der Forschergruppe von Professor Vahid Sandoghdar t?tig. Toninellis wissenschaftliche Arbeit ist herausragend und es ist ihr gelungen, ein eigenes Forschungsfeld im Bereich Molecular Nanophotonics zu formulieren. Ihr für den Caroline-von-Humboldt-Preis vorgeschlagenes Projekt Organic Molocules in Disordered Photonic Structures ist ausgesprochen innovativ und wird eingebettet am Humboldt-Zentrum für Moderne Optik innerhalb des Integrative Research Institute for the Sciences, IRIS Adlershof. Toninelli wird vom DFG-Forschungsprojekt Hybrid Inorganic-orgnic systems (HIOS) als Gastwissenschaftlerin eingeladen.
Costanza Toninelli hat den Caroline-von-Humboldt-Preis am 2. November 2011 erhalten.
?
Preistr?gerin 2010

Anne Baillot
Die Literaturwissenschaftlerin und Emmy-Noether-Nachwuchsgruppenleiterin forscht am Institut für deutsche Literatur über "Berliner Intellektuelle 1800-1830" und nimmt dabei auch die Universit?t, insbesondere die Philosophische Fakult?t, ins Augenmerk. Anne Baillot untersucht die Berliner intellektuellen Netzwerke mit dem Ziel, mehr über die kulturelle und politische Entwicklung der Stadt des angehenden 19. Jahrhunderts zu erfahren.
Für diese Forschungsarbeit wurde ihr am 13. Oktober 2010 der Caroline-von-Humboldt-Preis verliehen.
?
.jpg)